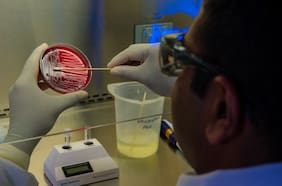

infección
27 OCTUBRE
El Ministerio de Salud de Perú declaró una alerta epidemiológica por un brote de la bacteria Ralstonia pickettii, vinculado a un fármaco contaminado que fue suministrado en clínicas y hospitales.
Qué es la bacteria Ralstonia picketti que infectó a casi 30 personas por el uso de un fármaco en hospitales
26 AGOSTO
02 AGOSTO
El cantante reveló que fue diagnosticado con una infección transmitida por garrapatas, tras enfrentar dolor y fatiga durante su gira. La confesión llega luego de recibir críticas por presentaciones poco enérgicas en su show.
Qué es la enfermedad de Lyme, la infección por garrapatas que padece Justin Timberlake
28 MAYO
22 MAYO
El virus H5N1, que hasta ahora afectaba principalmente a aves, se propaga con rapidez entre gatos domésticos y grandes felinos. Científicos temen que su evolución lo acerque peligrosamente a los humanos.
La gripe aviar está matando gatos con una tasa de mortalidad del 90%: advierten que podría transmitirse a los humanos
05 ABRIL
10 MARZO
20 ENERO
20 DICIEMBRE
05 DICIEMBRE
29 SEPTIEMBRE
Lo más leído
2.
3.
4.